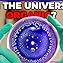

![[Q&A+] Organic Universe, Fighting Conspiracies, Most Anticipated Space Event | Q&A 379 Podcast Por capa](https://m.media-amazon.com/images/I/51aOKkHDRyL._SL500_.jpg)
[Q&A+] Organic Universe, Fighting Conspiracies, Most Anticipated Space Event | Q&A 379
Falha ao colocar no Carrinho.
Tente novamente mais tarde
Falha ao adicionar à Lista de Desejos.
Tente novamente mais tarde
Falha ao remover da Lista de Desejos
Tente novamente mais tarde
Falha ao adicionar à Biblioteca
Tente outra vez
Falha ao seguir podcast
Tente outra vez
Falha ao parar de seguir podcast
Tente outra vez
-
Narrado por:
-
De:
Sobre este título
Can the whole Universe be a giant organic organism? How to fight back conspiracy theories? Which astronomical even do I anticipate the most? And in Q&A+, who would I interview from the entire history, given such a possibility?
Watch the video here (with no ads) or on YouTube: https://youtu.be/JZnNPEJw8KY
Ainda não há avaliações